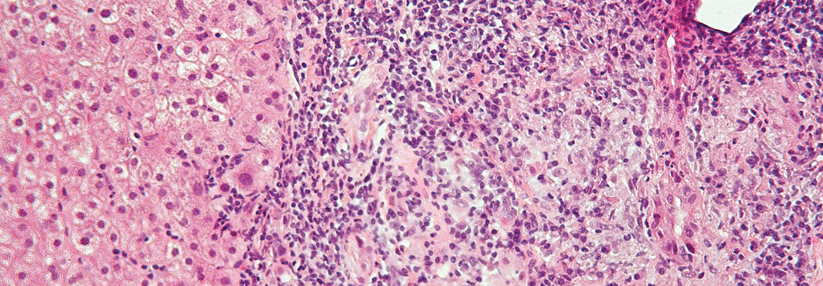

Biliär oder sklerosierend? Bei chronischer Cholestase autoimmun denken
 Die primär sklerosierende Cholangitis trifft häufiger Männer, die primär biliäre Cholangitis öfter Frauen.
© iStock/Rasi Bhadramani
Die primär sklerosierende Cholangitis trifft häufiger Männer, die primär biliäre Cholangitis öfter Frauen.
© iStock/Rasi Bhadramani
Die primär biliäre Cholangitis (PBC) ist mit einem Anteil von 80–90 % vor allem eine Erkrankung von Frauen, erklärte Prof. Dr. Christoph Schram von der Medizinischen Klinik I an der Universitätsklinik HH-Eppendorf. Die Prävalenz liegt bei 40/100.000 und das mittlere Erkrankungsalter bei 50 bis 60 Jahren. Die Diagnose kann gestellt werden, wenn zwei der folgenden drei Kriterien erfüllt sind:
- chronische Cholestase
- antimitochondriale Antikörper (AMA, bei über 90 % positiv) oder typische antinukleäre Antikörper (ANA, etwa 70 % der AMA-negativen Patienten)
- typische Histologie
Bei den seltener erkrankten Männern wird die PBC oft erst sehr spät erkannt. Ihr Verlauf ist deutlich schlechter,…
Liebe Leserin, lieber Leser, aus rechtlichen Gründen ist der Beitrag, den Sie aufrufen möchten, nur für medizinische Fachkreise zugänglich. Wenn Sie diesen Fachkreisen angehören (Ärzte, Apotheker, Medizinstudenten, medizinisches Fachpersonal, Mitarbeiter der pharmazeutischen oder medizintechnischen Industrie, Fachjournalisten), loggen Sie sich bitte ein oder registrieren sich auf unserer Seite. Der Zugang ist kostenlos.
Benutzeranmeldung
Bitte geben Sie Ihren Benutzernamen und Ihr Passwort ein, um sich an der Website anzumelden.
Bei Fragen zur Anmeldung senden Sie bitte eine Mail an online@medical-tribune.de.